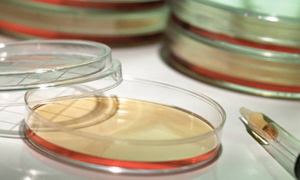
Microbial Identification
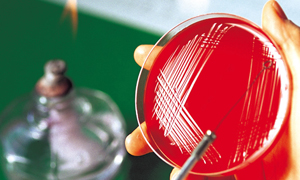
Phenotypic Identification

At MEI, we provide contract microbiological testing from process and method development through manufacturing
in full compliance with cGMP regulations.
We offer a range of microbial identification related services for single sample through bulk sample, bulk sample contracts and extensive ongoing projects..
Our services are designed to give our customers flexibility for routine testing, consulting and timely assistance in an emergency response.
For more information, please contact MEI Customer Service at customerservice@molecularepi.com